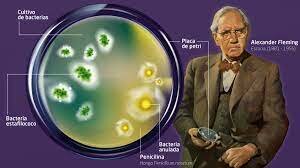
Descubrimiento de la penicilina

-
El humanismo renacentista es un movimiento intelectual y filosófico europeo estrechamente ligado al Renacimiento . Este período se caracterizó por el florecimiento de las artes, la filosofía y las culturas en Europa. ver al ser humano como aquel que tiene potencial .desde su intelecto y creatividad lograr entender cómo funciona el mundo para cambiarlo.
-
Dentro de sus rasgos mas significativos encontramos el rechazo a la escolástica y el fomento de los estudios no religiosos,
el énfasis en el individuo y su autonomía moral , la creencia en la importancia de la observación, el análisis crítico y la creatividad
la creencia de que los poetas, los escritores y los artistas pueden llevar a la humanidad a una mejor forma de vida
además de un interés por la pregunta «¿qué significa ser humano?» -
 La imprenta de Gutenberg, inventó lo esencial que da comienzo a la cultura escrita; el interés por estudiar la literatura y el arte de la antigüedad
La imprenta de Gutenberg, inventó lo esencial que da comienzo a la cultura escrita; el interés por estudiar la literatura y el arte de la antigüedad -
 El gran mecenas de los tiempos del Renacimiento
El gran mecenas de los tiempos del Renacimiento
es considerado el padre o el cerebro detrás de la revolución que implicó el Renacimiento. Ello en parte se debe al patrocinio que ejerció sobre todo en el aspecto cultural y artístico. Fue una auténtica revolución creativa -
 El intelectual italiano Giovanni Pico de lla Mirandola fue el primero en designar el término humanismo para designar al movimiento.
El intelectual italiano Giovanni Pico de lla Mirandola fue el primero en designar el término humanismo para designar al movimiento. -
 Erasmo de Rotterdam Fue un defensor de la libertad, y frente al «De servo arbitrio» de Lutero, publicó «De libero arbitrio», una de las más hermosas definiciones de la libertad humana. Defendió además con pertinacia callada y tenaz su propia libertad personal, tanto intelectual como moral, lo que le trajo problemas graves con la Iglesia.
Erasmo de Rotterdam Fue un defensor de la libertad, y frente al «De servo arbitrio» de Lutero, publicó «De libero arbitrio», una de las más hermosas definiciones de la libertad humana. Defendió además con pertinacia callada y tenaz su propia libertad personal, tanto intelectual como moral, lo que le trajo problemas graves con la Iglesia. -
 La conquista de los españoles tuvo un enorme impacto en América. Se introdujo el conocimiento indígena en arte e ingeniería, además de diferentes especies vegetales y animales, como el caballo, especie introducida en el segundo viaje de Cristóbal Colón, y que se encontraba extinto en América desde tiempos remotos.
La conquista de los españoles tuvo un enorme impacto en América. Se introdujo el conocimiento indígena en arte e ingeniería, además de diferentes especies vegetales y animales, como el caballo, especie introducida en el segundo viaje de Cristóbal Colón, y que se encontraba extinto en América desde tiempos remotos. -
 Luis Vives (1492-1540), de padres judeoconversos, estudió lógica y filosofía en la Universidad de la Sorbona de París siendo, Los últimos años de su vida los dedicó a perfeccionar el humanismo renacentista, se convirtió en un reformador de la educación europea y en un filósofo moralista de talla universal. Vives realizó en Brujas su obra «Tratado del socorro de los pobres«, en la que analizaba y sistematizaba la organización de ayuda a los pobres y cómo debía hacerse
Luis Vives (1492-1540), de padres judeoconversos, estudió lógica y filosofía en la Universidad de la Sorbona de París siendo, Los últimos años de su vida los dedicó a perfeccionar el humanismo renacentista, se convirtió en un reformador de la educación europea y en un filósofo moralista de talla universal. Vives realizó en Brujas su obra «Tratado del socorro de los pobres«, en la que analizaba y sistematizaba la organización de ayuda a los pobres y cómo debía hacerse -
 Su teoría Consistía en la idea del ser humano como el centro de todas las cosas, en oposición al pensamiento teológico de la Edad Media en la que Dios era el centro de la vida. La figura del dios creador. Seguía siendo relevante, dado que cumplía un rol fundamental en la concepción del universo. El uso de la razón sobre la fe
Su teoría Consistía en la idea del ser humano como el centro de todas las cosas, en oposición al pensamiento teológico de la Edad Media en la que Dios era el centro de la vida. La figura del dios creador. Seguía siendo relevante, dado que cumplía un rol fundamental en la concepción del universo. El uso de la razón sobre la fe -
 Georg Friedrich Daumer Fue un poeta y filósofo alemán. Cursó el bachillerato en el Gymnasium de su ciudad natal, cuyo director era Hegel. En 1817 entró en la Universidad de Erlangen como estudiante de teología, pero la abandonó por la filosofía. Durante años fue profesor en el Gymnasium de Núremberg; debido a su mala salud, se le concedió una excedencia con pensión y desde entonces se dedicó por entero a la literatura.
Georg Friedrich Daumer Fue un poeta y filósofo alemán. Cursó el bachillerato en el Gymnasium de su ciudad natal, cuyo director era Hegel. En 1817 entró en la Universidad de Erlangen como estudiante de teología, pero la abandonó por la filosofía. Durante años fue profesor en el Gymnasium de Núremberg; debido a su mala salud, se le concedió una excedencia con pensión y desde entonces se dedicó por entero a la literatura. -
El Humanismo Exótico, es el segundo humanismo planteado por el antropólogo, filósofo y etnólogo francés Lévi-Strauss.Se construye sobre la consciencia de una visión mundial de la humanidad y que la civilización occidental coexiste junto a otros imaginarios y culturas diferentes, igualmente valida.
-
 Guerras Napoleónicas también llamadas guerras de la Coalición,33 fueron una serie de conflictos bélicos que tuvieron lugar durante el tiempo en que el emperador Napoleón I Bonaparte gobernó en Francia. Fueron en parte una extensión de los conflictos que estallaron a causa de la Revolución francesa y continuaron, a instigación y gracias al financiamiento del Reino Unido de Gran Bretaña e Irlanda, durante todo el Primer Imperio francés.
Guerras Napoleónicas también llamadas guerras de la Coalición,33 fueron una serie de conflictos bélicos que tuvieron lugar durante el tiempo en que el emperador Napoleón I Bonaparte gobernó en Francia. Fueron en parte una extensión de los conflictos que estallaron a causa de la Revolución francesa y continuaron, a instigación y gracias al financiamiento del Reino Unido de Gran Bretaña e Irlanda, durante todo el Primer Imperio francés. -
 La primera locomotora de vapor fue construida por Richard Trevithick en 1804, 10 años antes de la máquina de George Stephenson. Esta máquina no dio resultado porque circulaba por rieles de hierro fundido inapropiados para su peso.
La primera locomotora de vapor fue construida por Richard Trevithick en 1804, 10 años antes de la máquina de George Stephenson. Esta máquina no dio resultado porque circulaba por rieles de hierro fundido inapropiados para su peso. -
 Independencia de Colombia (1810-1819)La independencia de Colombia fue el proceso histórico que dio por terminada la etapa regentada por el Imperio español en el actual territorio del país. Dicho proceso se libró en medio de un conflicto desarrollado entre 1810 a 1819, conflicto que se libró para emancipar los territorios que entonces comprendían el Virreinato de la Nueva Granada.
Independencia de Colombia (1810-1819)La independencia de Colombia fue el proceso histórico que dio por terminada la etapa regentada por el Imperio español en el actual territorio del país. Dicho proceso se libró en medio de un conflicto desarrollado entre 1810 a 1819, conflicto que se libró para emancipar los territorios que entonces comprendían el Virreinato de la Nueva Granada. -
 Schopenhauer afirmó que la existencia es sufrimiento, y también que la contemplación estética de las cosas y los hechos del mundo nos proporciona un estado de beatitud que aleja los males inherentes al tremendo hecho de vivir.
Schopenhauer afirmó que la existencia es sufrimiento, y también que la contemplación estética de las cosas y los hechos del mundo nos proporciona un estado de beatitud que aleja los males inherentes al tremendo hecho de vivir. -
 Fue un notable y polémico filólogo y filósofo alemán autor de las obras Así habló Zaratustra, La voluntad de poder, El origen de la tragedia, Gaya Ciencia, Verdad y mentira en sentido extramoral, entre otras.
Fue un notable y polémico filólogo y filósofo alemán autor de las obras Así habló Zaratustra, La voluntad de poder, El origen de la tragedia, Gaya Ciencia, Verdad y mentira en sentido extramoral, entre otras. -
 Pesimismo, es un estado de ánimo y una doctrina filosófica que sostiene que vivimos en el peor de los mundos posibles
Pesimismo, es un estado de ánimo y una doctrina filosófica que sostiene que vivimos en el peor de los mundos posibles
Nihilismo, es el rechazo de todos los principios religiosos y morales, a menudo en la creencia de que la vida no tiene sentido.
El ateísmo es la ausencia de la creencia en la existencia de las deidades.
El antinatalismo es la posición filosófica contraria a la reproducción y el nacimiento de nuevos seres humanos. -
 Enfermedades infecciosas (sífilis, tuberculosis) o relacionadas con la mala alimentación (pelagra, raquitismo, escorbuto).
Enfermedades infecciosas (sífilis, tuberculosis) o relacionadas con la mala alimentación (pelagra, raquitismo, escorbuto).
Se verá nacer la medicina experimental de Claude Bernard, la teoría de Omnia, la teoría de la evolución de las especies de Charles Darwin, y la genética de Gregor Mendel. -
 La Segunda Revolución Industrial se refiere a los cambios interrelacionados que se produjeron , cuando se inicia la Primera Guerra Mundial. Durante este tiempo los cambios sufrieron una fuerte aceleración. El proceso de industrialización cambió su naturaleza y el crecimiento económico varió de modelo.
La Segunda Revolución Industrial se refiere a los cambios interrelacionados que se produjeron , cuando se inicia la Primera Guerra Mundial. Durante este tiempo los cambios sufrieron una fuerte aceleración. El proceso de industrialización cambió su naturaleza y el crecimiento económico varió de modelo. -
Es una filosofía que orienta la manera de formar al hombre enfatizando la capacidad de éste para interpretar y entender la realidad que lo rodea, para ello determina como base fundamental la condición humana, así como los niveles de adecuación del individuo con su medio.
-
 Como nacionalista africano y marxista, Su lucha contra la impunidad fue permanente, por lo que después fue Premio Nobel de la Paz y recibió diversos reconocimientos más, como la Medalla Presidencial de la libertad y el Premio Lenin de la Paz
Como nacionalista africano y marxista, Su lucha contra la impunidad fue permanente, por lo que después fue Premio Nobel de la Paz y recibió diversos reconocimientos más, como la Medalla Presidencial de la libertad y el Premio Lenin de la Paz -
El descubrimiento de la penicilina en 1928 por el escocés Alexander Fleming es el caso de serendipia o descubrimiento accidental más importante de la historia
El descubrimiento de la penicilina en 1928 por el escocés Alexander Fleming es el caso de serendipia o descubrimiento accidental más importante de la historia -
 Formación del hombre para el desarrollo endógeno: éste pretende que el hombre utilice sus capacidades cognitivas y experiencias para crear bienes y servicios que satisfagan las necesidades de la comunidad local, generar nuevos espacios para convivir y construir su propio modo de vida sostenible.
Formación del hombre para el desarrollo endógeno: éste pretende que el hombre utilice sus capacidades cognitivas y experiencias para crear bienes y servicios que satisfagan las necesidades de la comunidad local, generar nuevos espacios para convivir y construir su propio modo de vida sostenible. -
 La revolución digital es un proceso de cambio que ha experimentado nuestra sociedad y sigue experimentando cada día. Con la aparición de tecnologías como las analógicas, después las mecánicas y electrónicas, y finalmente la tecnología digital, han provocado un cambio disruptivo en la sociedad y la economía.
La revolución digital es un proceso de cambio que ha experimentado nuestra sociedad y sigue experimentando cada día. Con la aparición de tecnologías como las analógicas, después las mecánicas y electrónicas, y finalmente la tecnología digital, han provocado un cambio disruptivo en la sociedad y la economía. -
 Nació ARPANET, la primera conexión entre los ordenadores de Standford y UCLA.
Nació ARPANET, la primera conexión entre los ordenadores de Standford y UCLA. -
 El primer teléfono inteligente fue diseñado por IBM en 1992 y se llamó Simón. Fue mostrado como un producto concepto en ese año en la expo COMDEX. Fue liberado al público en 1993 y comercializado por BellSouth.
El primer teléfono inteligente fue diseñado por IBM en 1992 y se llamó Simón. Fue mostrado como un producto concepto en ese año en la expo COMDEX. Fue liberado al público en 1993 y comercializado por BellSouth. -
 El actor más importante es, sin duda, Facebook. El servicio vincula a los internautas entre sí, dándoles la posibilidad de crear redes y subredes donde intercambiar información, fotografías, vídeo, y todo lo que, en resumen, constituye su vida digital. otras redes como Instagram entre otros con gran acogida en la humanidad
El actor más importante es, sin duda, Facebook. El servicio vincula a los internautas entre sí, dándoles la posibilidad de crear redes y subredes donde intercambiar información, fotografías, vídeo, y todo lo que, en resumen, constituye su vida digital. otras redes como Instagram entre otros con gran acogida en la humanidad -
 La nube permite almacenar y acceder a datos y programas a través de internet.
La nube permite almacenar y acceder a datos y programas a través de internet. -
 Es un ingeniero en computación y empresario estadounidense, creador junto con Serguéi Brin de Google (Alphabet).Clasificado como la 5.ª persona más rica del mundo .2 Es conocido por haber creado el algoritmo matemático "PageRank", el buscador web de Internet con un crecimiento de 95%.
Es un ingeniero en computación y empresario estadounidense, creador junto con Serguéi Brin de Google (Alphabet).Clasificado como la 5.ª persona más rica del mundo .2 Es conocido por haber creado el algoritmo matemático "PageRank", el buscador web de Internet con un crecimiento de 95%. -
El humanismo digital considera humanizar la tecnología y ponerla al servicio de las personas con el objetivo de mejorar su bienestar personal.
-
 Los primeros reproductores MP3 con disco duro fueron lanzados en 2000 y recordamos la impresión que causó Creativ Nomad, con su disco duro de 6 GB y batería para 3 horas.
Los primeros reproductores MP3 con disco duro fueron lanzados en 2000 y recordamos la impresión que causó Creativ Nomad, con su disco duro de 6 GB y batería para 3 horas. -
 Google, es una compañía principal subsidiaria de la estadounidense Alphabet cuya especialización son los productos y servicios relacionados con internet, software, dispositivos electrónicos y otras tecnologías.
Google, es una compañía principal subsidiaria de la estadounidense Alphabet cuya especialización son los productos y servicios relacionados con internet, software, dispositivos electrónicos y otras tecnologías. -
 Internet de banda ancha es actualmente un elemento tan natural como la electricidad en un gran número de hogares.
Internet de banda ancha es actualmente un elemento tan natural como la electricidad en un gran número de hogares. -
 Covid-19
Covid-19
Enfermedad respiratoria muy contagiosa causada por el virus SARS-CoV-2. Se piensa que este virus se transmite de una persona a otra en las gotitas que se dispersan cuando la persona infectada tose, estornuda o habla.. Los signos y síntomas más frecuentes de la COVID-19 son fiebre, tos y dificultad para respirar.
Plan projects on a visual timeline
Map milestones, phases, deadlines, and key events in one place so the sequence is easier to see and share. Timetoast is a timeline maker for work, school, research, and stories.
